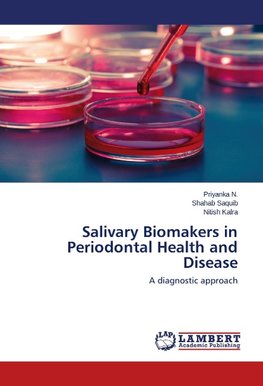
Salivary Biomakers in Periodontal Health and Disease

-
 Anglický jazyk
Anglický jazyk
Salivary Biomakers in Periodontal Health and Disease
Autor: Priyanka N.
This book provides information on biomarkers found in oral fluids relevant to oral and systemic diseases, with emphasis on salivary molecules and their potential to provide screening diagnosis for periodontal disease. The book will provide greater impact... Viac o knihe
Na objednávku
36.99 €
bežná cena: 41.10 €
O knihe
This book provides information on biomarkers found in oral fluids relevant to oral and systemic diseases, with emphasis on salivary molecules and their potential to provide screening diagnosis for periodontal disease. The book will provide greater impact on clinician education in diagnostics, disease-risk and disease prevention through the public health sector before diagnostics will be integrated into routine clinical periodontal practice. Although challenges remain ahead, the use of saliva based oral fluid diagnostics appear promising for future application to diagnose periodontal diseases and to prognosticate periodontal treatment outcomes.
- Vydavateľstvo: LAP LAMBERT Academic Publishing
- Rok vydania: 2014
- Formát: Paperback
- Rozmer: 220 x 150 mm
- Jazyk: Anglický jazyk
- ISBN: 9783659625749





 Nemecký jazyk
Nemecký jazyk 






